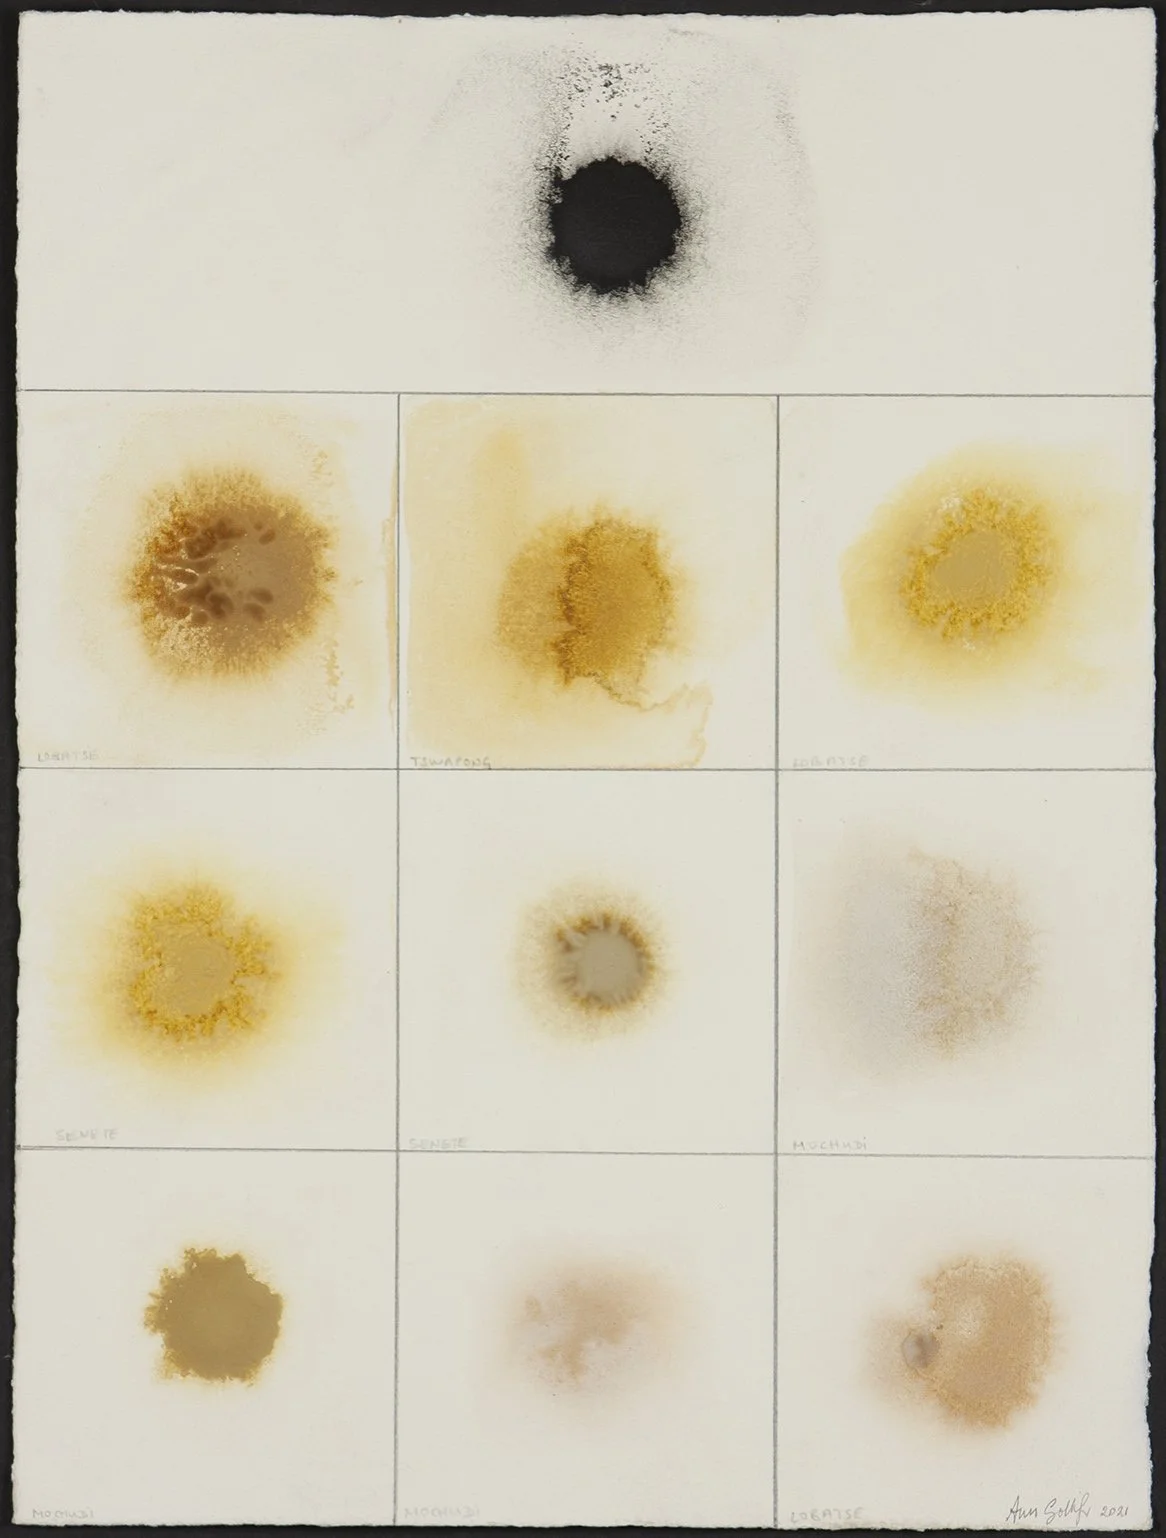

2021 - Botswana Ochres
I have started making my own watercolours using the Botswana ochres suspended in Gum Arabic. As I mix an earth pigment, I notice it’s texture, finer or grainier depending on the colour. Some ochres take longer to be mulled into a workable paste. Some are grainier, some smoother. Some are translucent and other opaque. Some smell like damp clay, or the dusty scent of a dogs paw. Some are sweet like wet earth after rain. I can understand how the first people took this beautiful paste and smeared it onto their skin, covering their bodies with it. They clothed themselves in earth for protection from the sun and the wind. They did it for protection from the biting insects. They also clothed themselves in the earth to try to conquer nature. The ochres gave them shape-shifting powers, disguising their colour, smell, form and movement. Did they also clothe themselves in the ochres to honour and worship nature? What came first? The worship of the ochres, from the commonest to the rarest ones, or their use for protection and conquest? I think about the human race and our place in nature. It is strange to think that perhaps one day there will be nothing left of us but some bones laid down in sediments, like the dinosaurs. Is painting, as a human activity, still linked to our desire to exalt and conquer nature, and life and death itself?